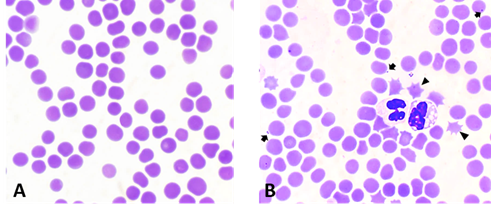

Đặc tính sinh lý và sinh hóa máu của lợn mắc bệnh do Mycoplasma suis và ứng dụng nhuộm Giemsa trong chẩn đoán
Cập nhật lúc 15:00, Thứ sáu, 23/01/2026 (GMT+7)
Bệnh do Mycoplasma suis là một trong những nguyên nhân quan trọng ảnh hưởng đến sức khỏe đàn lợn và hiệu quả chăn nuôi tại Việt Nam. Nhằm làm rõ những biến đổi về sinh lý và sinh hóa máu ở lợn mắc bệnh do Mycoplasma suis, đồng thời đánh giá khả năng ứng dụng phương pháp nhuộm Giemsa trong chẩn đoán, nhóm tác giả thuộc Khoa Thú y – Học viện Nông nghiệp Việt Nam đã thực hiện nghiên cứu “Đặc tính sinh lý và sinh háo máu của lợn mắc bệnh do Mycoplasma suis và ứng dụng nhuộm Giemsa trong chẩn đoán” và công bố kết quả trên tạp chí khoa học chuyên ngành.
Bệnh do Mycoplasma suis là một trong những nguyên nhân ảnh hưởng đến sức khỏe đàn lợn và hiệu quả chăn nuôi. Nghiên cứu được thực hiện nhằm so sánh các chỉ tiêu huyết học và sinh hóa máu giữa lợn khỏe mạnh và lợn mắc bệnh, qua đó đánh giá giá trị của các chỉ số này trong chẩn đoán bệnh.
    |
 |
| Hình 1. Hình ảnh đồ thị Realtime PCR xác định sự có mặt của M. suis |
Qua nghiên cứu cho thấy chỉ số huyết học như RBC, HCT, MCH và MCHC ở lợn mắc bệnh giảm thấp hơn so với lợn khỏe (P <0,05). Một số chỉ tiêu sinh hóa máu gồm AST, bilirubin gián tiếp và creatinin ở nhóm lợn bệnh tăng cao (P <0,05), trong khi đường huyết giảm rõ rệt.
Quan sát tiêu bản máu sau nhuộm Giemsa cho thấy Mycoplasma suis có dạng tròn hoặc bầu dục, bắt màu tím, bám trên bề mặt hồng cầu hoặc phân bố rải rác trong huyết tương, phản ánh rõ tình trạng nhiễm bệnh.
    |
|
| Hình 2. Hồng cầu lợn khoẻ (A) và lợn mắc M. suis (B) với sự xuất hiện |
    |
 |
Hình 3. Hình ảnh hồng cầu biến dạng hình sao (đầu mũi tên) ở nhiều mức độ khác nhau:
rải rác (A) và biến dạng hầu hết toàn bộ (B) (Giemsa, 100X) |
Kết quả nghiên cứu cho thấy các chỉ tiêu huyết học và sinh hóa máu có ý nghĩa trong việc xác định và đánh giá mức độ nhiễm Mycoplasma suis ở lợn. Đặc biệt, phương pháp nhuộm Giemsa với kỹ thuật đơn giản, dễ triển khai, phù hợp với điều kiện thực tế tại Việt Nam, được ứng dụng hiệu quả trong công tác chẩn đoán bệnh tại các cơ sở thú y, nghiên cứu và đào tạo.
Nghiên cứu cũng góp phần bổ sung cơ sở khoa học phục vụ công tác phòng, chẩn đoán và kiểm soát bệnh do Mycoplasma suis trong chăn nuôi lợn và hướng tới phát triển chăn nuôi bền vững.
Chi tiết xem tại: https://vie.vjas.vn/index.php/vjasvn/article/view/1867/2280
Đào Hương – Nhà xuất bản